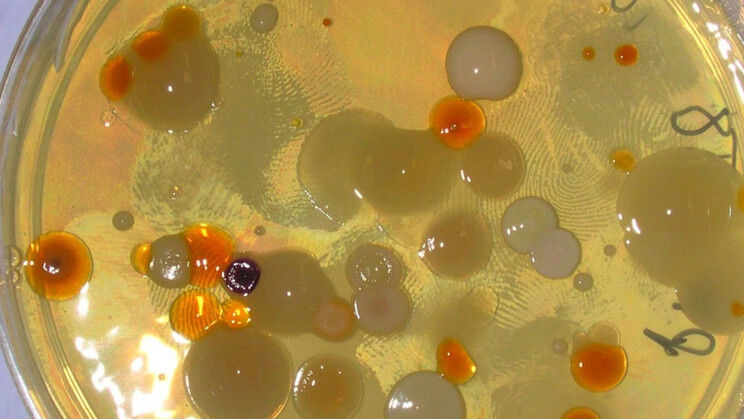

1809/2021
Nhà khoa học Việt chế tạo 'mắt thông minh' phòng Covid-19
Mắt thông minh - CLi SmartEyes sẽ giúp tự động kiểm soát tại các điểm công cộng, phát hiện người bị sốt, lịch sử dịch tễ thay người đứng chốt.

0709/2021
Nano bạc - gia tăng hiệu quả vi nhân giống cây Dâu tây, chất khử trùng trong vi nhân giống cây Cúc
các nhà khoa học Viện Nghiên cứu khoa học Tây Nguyên đã nghiên cứu ảnh hưởng của các hạt nano bạc đối với việc khử trùng mẫu cấy, sự sinh trưởng của mẫu cấy in vitro (nhân chồi và ra rễ), cũng như sự tích lũy khí ethylene trong quá trình vi nhân giống cây Dâu tây.

0609/2021
"Mánh khóe" xâm lược tế bào của SARS-CoV-2
Các nhà khoa học ngày càng hiểu rõ về vòng đời của SARS-CoV-2 và “mánh khóe xâm lược” của chúng.

2808/2021
Hợp chất Vernoamyosit E từ cây lá đắng
Hợp chất Vernoamyosit E được các nhà khoa học của Viện Nghiên cứu khoa học Miền Trung tìm ra trong cây lá đắng góp phần tạo cơ sở khoa học cho các nghiên cứu ứng dụng nhằm tạo ra các sản phẩm có tác dụng phòng và điều trị bệnh đái tháo đường dựa trên nguồn dược liệu có sẵn có trong nước.

2808/2021
Ra mắt mạng lưới hợp tác về Trí tuệ nhân tạo tại Việt Nam
Mạng lưới hợp tác về Trí tuệ nhân tạo Việt - Úc (Vietnam - Australia AI) do Bộ Khoa học và Công nghệ khởi xướng, chủ trì, nằm trong khuôn khổ của Chương trình quảng bá chiến lược quốc gia về trí tuệ nhân tạo.
2608/2021
Vi khuẩn vẫn sống sót khi nhịn đói trong 1.000 ngày
Chúng ta vẫn biết rằng vi khuẩn có thể được hồi sinh trong mọi thứ, từ băng đến trầm tích dưới đáy biển 100 triệu năm tuổi, thậm chí chúng còn có thể sống sót trên sao Hoả. Gần đây, một nghiên cứu mới tiết lộ rằng vi khuẩn còn có thể tồn tại mà không cần thức ăn.

2108/2021
Nguy cơ xuất hiện các biến thể mới: Đâu là lối thoát ?
Các nhà khoa học Anh cảnh báo trước nguy cơ hình thành các đột biến của virus corona có khả năng kháng vaccine. Đâu là lối thoát?

1808/2021
Học máy tìm đột biến trong các trình tự hệ gene tương đồng của các mẫu ung thư
Một nhóm các nhà nghiên cứu làm việc tại Viện nghiên cứu Francis Crick đã phát triển một cách để tìm các đột biến trong nhũng vùng của hệ gene tương đồng của các mẫu ung thư.

1808/2021
Liều thứ ba an toàn và hiệu quả đến đâu?
Các nhà sản xuất vaccine đưa ra các dữ liệu mới cho thấy tiêm bổ sung đợt ba không có gì đáng ngại và có hiệu quả. Các nhà quản lý cũng như Ủy ban thường trực tiêm chủng quốc gia Đức (Stiko) cho đến nay cảm thấy vấn đề này chưa thuyết phục. Vậy hiện tại khoa học nói gì về mũi tiêm thứ ba.

1708/2021
Vi khuẩn bảo vệ ruột khỏi sự xâm nhập của virus SARS-CoV-2
Các nhà nghiên cứu từ Đại học Yonsei ở Hàn Quốc đã phát hiện ra vi khuẩn hội sinh sống trong ruột người sản sinh các hợp chất ức chế virus SARS- CoV-2.

1608/2021
Vệ tinh ‘made in Việt Nam’ chuẩn bị được phóng lên vũ trụ
Vệ tinh NanoDragon đã được chuyển đi từ sân bay Nội Bài đến sân bay Narita, Tokyo. Sau đó, vệ tinh sẽ được chuyển về bãi phóng Trung tâm Vũ trụ Uchinoura, tỉnh Kagoshima và được bàn giao cho Cơ quan Hàng không Vũ trụ Nhật bản (JAXA) để chuẩn bị phóng lên vũ trụ.